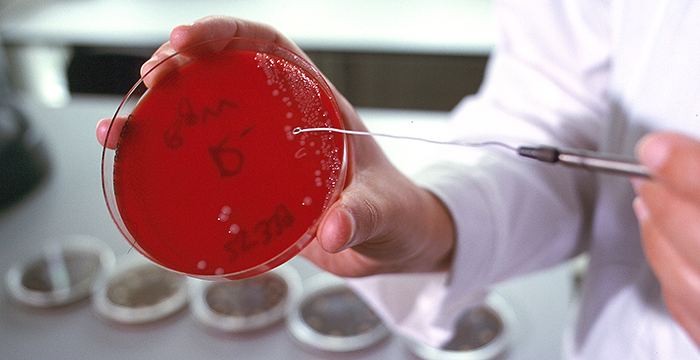

Vorbeugen ist besser als heilen
Die gemeinschaftliche Tiergesundheitspolitik verfolgt das Motto "Vorbeugen ist besser als Heilen" (Tiergesundheitsstrategie der Europäischen Union 2007–2013).
Das primäre Ziel ist somit auch in Baden-Württemberg, die Erkrankung von Tieren durch verhindernde Maßnahmen, wie Impfungen und die Einhaltung von Biosicherheitsmaßnahmen, so gut wie möglich zu vermeiden. Aber nicht immer kann das Auftreten einer Tiererkrankung vermieden werden, so dass im positiven Fall so schnell wie möglich und so effektiv wie möglich gehandelt werden muss, um eine Ausbreitung zu verhindern. Denn Tierkrankheiten, wie die hoch ansteckende Schweinepest, Maul- und Klauenseuche oder auch die Geflügelpest (Vogelgrippe) können zu erheblichen Tierverlusten und beträchtlichen wirtschaftlichen Verlusten führen. Ein konsequentes Vorgehen ist auch bei Zoonosen (beispielsweise Salmonellose) geboten, den hier ist neben dem Tier auch die Gesundheit des Menschen gefährdet.
Um das Auftreten einer Erkrankung möglichst schnell zu erkennen, ist der Tierhalter verpflichtet, Auffälligkeiten zu melden. Zusätzlich werden regelmäßig labordiagnostische Untersuchungen durchgeführt.
Diese Laboruntersuchungen werden an den Chemischen und Veterinäruntersuchungs- ämtern Stuttgart, Karlsruhe, Freiburg sowie am Staatlichen Tierärztlichen Untersuchungsamt Aulendorf vorgenommen.
Auf den folgenden Seiten finden Sie einige weiterführende Informationen zu ausgewählten Tiererkrankungen.
Tiererkrankungen (Links auf die Internetseite des Ministeriums für Ländlichen Raum und Verbraucherschutz)
- Afrikanische Schweinepest (ASP)
- BHV1 – Bovine Herpesvirus Typ 1
- BVD – Bovine Virus Diarrhoe
- Vogelgrippe
- LPAI – niedrigpathogene aviäre Influenza
- BT – Blauzungenkrankheit
- BSE – Bovine Spongiforme Enzephalopathie
- Tollwut
- MKS – Maul- und Klauenseuche
- Europäische Schweinepest
- Varroose bei Bienen
- Schmallenberg-Virus